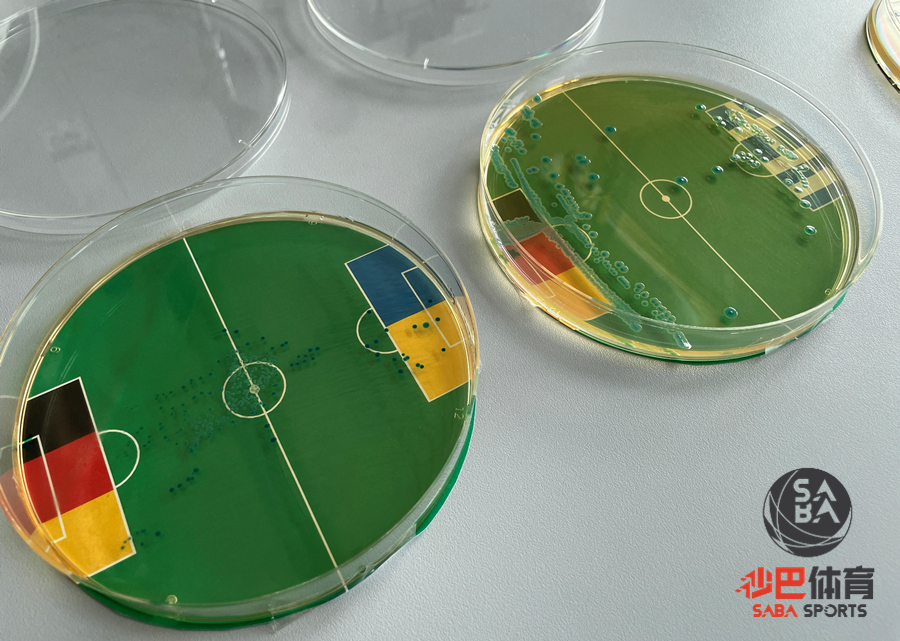

Source:REUTERS/ Christine Uyanik
[足球外围平台sabasports ]在开幕式上燃放烟花,已成为所有大型赛事的标配。但即将举行的德国欧洲杯开幕式上,球迷可能看不到烟花的踪影。据德国媒体《图片报》报道,欧足联计划在安联球场举行的欧洲杯开幕式上燃放60发烟花,称其为“仪式的一大亮点”,但慕尼黑当局并不同意这一做法。根据慕尼黑的地方法规,所有的烟花表演必须得到慕尼黑市政府的批准。对此,慕尼黑市政府的消防部门发言人表示,早在2024年1月,市政府已呼吁组织者EURO 2024 GmbH不要在开幕式上使用任何烟花。这一做法将对球迷起到示范效应,因为任何未经授权使用的烟花,都有可能导致比赛的中断,危害球迷和球员的生命安全。对此,欧足联方面予以反驳,表示开幕式的策划和组织都受到严格的监管,由知名制造商和专业公司参与,严格符合主办国的健康和安全法规。对此,有球迷表示,今年欧冠杯1/4决赛首回合拜仁作客阿森纳,拜仁球迷被禁止入场观赛,原因是拜仁球迷在上一个客场燃放了烟花。明显,慕尼黑市政府怀恨在心,故意刁难欧足联。
